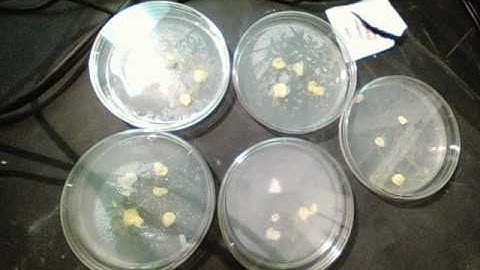
Physarum Polycephalum - Camera #3

⬇ DOWNLOAD NOW
Kalau muncul iklan pop-up, tutup lalu klik tombol kembali
Download lagu Physarum Polycephalum - Camera #1 secara gratis hanya untuk keperluan promosi. Dukung artis favorit kamu dengan membeli musik original di iTunes atau platform resmi lainnya.
 Physaryum Polycephalum timelapse #1
Physaryum Polycephalum timelapse #1
 Can Slime Mould Solve Mazes? | Earth Science
Can Slime Mould Solve Mazes? | Earth Science
 Strange Growths | Physarum Polycephalum
Strange Growths | Physarum Polycephalum
 Slime mold form a map of the Tokyo-area railway system
Slime mold form a map of the Tokyo-area railway system
 Physarum Polycephalum | Protrusion | Microscopy (4K)
Physarum Polycephalum | Protrusion | Microscopy (4K)
 Physarum Polycephalum | Tubular Separation | Microscopy (4K)
Physarum Polycephalum | Tubular Separation | Microscopy (4K)
Physarum Polycephalum - Camera #3
Physarum Polycephalum - Camera #3
 Physarum Polycephalum | Dry Conditions (4K)
Physarum Polycephalum | Dry Conditions (4K)